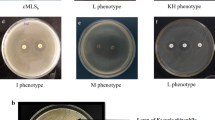

Abstract
The overuse of colistin, the last-resort antibiotic, has led to the emergence of colistin-resistant bacteria, which is a major concern. Lactic acid bacteria which are generally regarded as safe are known to be reservoirs of antibiotic resistance that possibly pose a threat to human and animal health. Therefore, this study assessed the prevalence of colistin antimicrobial resistance in livestock in India, that is lactic acid bacteria in healthy chickens, sheep, beef, and swine of Mysore. Diverse phenotypic and genotypic colistin resistance were examined among the lactic acid bacterial species (n = 84) isolated from chicken (n = 44), sheep (n = 16), beef (n = 14), and swine (n = 10). Hi-comb, double-disk diffusion tests, Minimum Inhibitory Concentration (MIC), and biofilm formation were assessed for phenotypic colistin resistance. Specific primers for colistin-resistant genes were used for the determination of genotypic colistin resistance. Around 20%, 18%, and 1% were colistin-resistant Lactobacillus, Enterococcus, and Pediococcus species, respectively. Among these, 66.67% exhibited MDR phenotypes, including colistin antibiotic. The identified resistant isolates are Levilactobacillus brevis LBA and LBB (2), Limosilactobacillus fermentum LBF (1), and Pediococcus acidilactici CHBI (1). The mcr-1 and mcr-3 genes were detected in Levilactobacillus brevis LBA, LBB, and Pediococcus acidilactici CHBI isolated from chicken and sheep intestines respectively. The study identified colistin resistance determinants in lactobacilli from food animals, emphasizing the need for enhanced surveillance and monitoring of resistance spread. These findings underscore colistin resistance as a significant medical concern and should be integrated into India’s ongoing antimicrobial resistance monitoring programs.
Research Highlights
-
The various LAB isolates identified at strain level are Levilactobacillus brevis LBB, Limosilactobacillus fermentum LBF, Pediococcus acidilactici CHBI, from different food animal sources.
-
The MIC assay displayed 66.67 % LAB isolates were exceptionally multidrug resistant.
-
Genotypic evaluation tests among the LAB isolates revealed the presence of mcr 1 and mcr 3 colistin-resistant genes.
Similar content being viewed by others
Avoid common mistakes on your manuscript.
Introduction
The spread of antimicrobial resistance among human, animal, and zoonotic pathogens is a major global concern. According to a report from the World Health Organization, the problem has reached alarming levels in many parts of the world, raising the possibility of a "post-antibiotic era" in the twenty-first century [1]. One particularly concerning aspect of this issue is the emergence of plasmid-mediated colistin resistance in the food chain. The treatment options for any life-threatening infection caused by carbapenemase-producing Enterobacteriaceae would be severely limited, relying on only two antibiotics, tigecycline and colistin [2]. In response to the increasing prevalence of multidrug-resistant (MDR) gram-negative Enterobacteriaceae, the use of polymyxins, particularly colistin, has increased as a treatment for gram-negative infections in many countries. A study unveiled a noteworthy occurrence of an Escherichia coli strain isolated from a 94-year-old patient with a urinary tract infection. The isolated strain co-harbouring resistance genes against both carbapenem and tetracycline, resulting in resistance to virtually all clinically utilized antibiotics [3]. Some of the infections caused by multidrug-resistant bacteria include urinary tract infections, bacteremia, bacterial skin infections, pulmonary infections, ventilator-associated pneumonia, ventilator-associated tracheobronchitis, etc., [4]. Bacterial virulence is characterized not only by the ability to induce disease but also by the capacity to invade and establish colonization within the host. Genetic virulence factors regulate several physical elements like flagella, pili, fimbriae, adhesins, biofilms, and biochemical factors such as host cell surface-modifying enzymes, toxins, and antibiotics. Genetically determined antimicrobial resistance can be considered a subset of virulence factors, facilitating host pathogenesis and enabling persistent or chronic diseases [5].
Antimicrobial resistance is a major global health concern, especially with the rise of multidrug-resistant organisms and a lack of new antibiotics for its treatment. At present, antibiotic resistance stands as one of the foremost challenges confronting global health and food security [6]. Colistin, an older antibiotic, has become increasingly important as a last-resort treatment for severe bacterial infections [7]. However, there has been a recent increase in colistin resistance, making it essential to understand the mechanisms behind this resistance.
Colistin resistance in gram-negative bacteria is primarily caused by structural modifications to the bacteria’s lipopolysaccharide. These modifications can occur through the addition of 4-amino-4-deoxy-l-arabinose or phosphoethanolamine following chromosomal mutations in genes such as PhoPQ and PmrAB, or through the use of the horizontally transferable plasmid-mediated colistin resistance gene, mcr-1 [7]. The mcr-1 gene has been found in over 20 countries worldwide and is prevalent in China, where it has been detected in 20% of animal strains and 1% of human strains [7, 8]. Colistin resistance is most commonly seen in E. coli, but is also found in other bacterial genera such as Klebsiella, Salmonella, Shigella, and Enterobacter [7]. The mcr-1 gene product alters the lipid A component of the bacterial outer membrane, reducing its susceptibility to colistin [7]. In addition to the mcr-1 gene, other colistin resistance genes have been identified, including mcr-2, mcr-3, mcr-4, mcr-5, mcr-6 and mcr-7. The mcr-2 gene is 76.7% identical to mcr-1 in terms of nucleotides and 81% identical in terms of amino acids [9]. It poses a similar threat to public health as mcr-1, but its transfer, origin, and mechanism of resistance are not well understood [10].
Although preventive or metaphylactic uses of colistin have been made in veterinary medicine, colistin resistance in bacteria obtained from animal sources is still uncommon in many developed nations [11]. Colistin has been used extensively as a veterinary treatment and as a growth booster in India. The fact that colistin is now only used as a last option to treat infections in people with cystic fibrosis or illnesses brought on by germs resistant to multiple drugs has also revived interest in the antibiotic for human usage [7]. The incidence of colistin resistance and the mcr-1 gene in the intestinal microbiota of food animals in India is not well understood, though. Multidrug-resistance has been increased all over the world which is considered a public health threat. Several recent investigations reported the emergence of multidrug-resistant bacterial pathogens from different origins that increase the necessity of new potent and safe alternatives for antibiotics such as probiotics. Besides, the routine application of antimicrobial susceptibility testing to detect the antibiotic of choice as well as the screening of the emerging MDR strains is most necessary. Therefore, this study aimed to determine the antimicrobial susceptibility of gram-positive lactic acid bacteria isolated from the intestines of food-producing animals and assess the degree of colistin resistance, such as the prevalence of mcr genes. This study serves as a sample of the current situation regarding colistin resistance in lactic acid bacteria of food-producing animals and provides significant information for further monitoring and preventing the spread of antibiotic resistance genes via the food chain.
Materials and Methods
Species Collection
The entire study was conducted between November 2019 and July 2021 at the CSIR-Central Food Technology Research Institute (CSIR-CFTRI), Mysore. Colistin-sensitive Lactococcus sp. T3.11 and E3.11 described in this paper are obtained from the Department of Microbiology and Fermentation Technology, CSIR-CFTRI.
Sampling, Bacterial Enumeration of Antibiotic-Resistant LAB
In this study, to investigate the occurrence of colistin-resistant bacteria, a total of 68 samples comprising chicken intestine (n = 44), sheep intestine (n = 16), beef intestine (n = 4), and swine intestine (n = 4) were collected randomly from different retail shops in Mysore city during November 2019. The intestines of food-producing animals were freshly collected aseptically in sterile containers using hand gloves from different retail shops in Mysore. The samples were brought to the lab and stored at -80˚C until further processing. Collected samples were cut into small pieces, and homogenized using physiological peptone saline (0.1% peptone + 0.85% NaCl) for meat samples, and aliquots of samples (1 mL of liquids samples) were serially diluted in physiological saline (8.5 g/L NaCl). The homogenized samples were serially diluted, and appropriate dilutions were plated onto De Man Rogosa and Sharpe (MRS; Himedia, Mumbai, India) agar containing (0 and 4 µg/mL) colistin (Sigma, India) according to the European Food Safety Authority [12] to enumerate sensitive and colistin-resistant LAB from the samples. After incubation, under microaerophilic conditions at 37 °C for 24 h, pure cultures were initially identified morphologically and microscopically and stored in MRS broth containing 20% glycerol at −20 °C.
Bacterial Isolation and Biochemical Identification
The isolates were revived from the glycerol stock onto the MRS agar media, and then cultured into fresh broth (MRS; Himedia, Mumbai, India) medium before use. The screening method was employed to isolate the colistin-resistant LAB stains. All isolates were subjected to gram reaction (crystal violet, gram’s iodine, safranin procured from Himedia, Mumbai, India), catalase (3% H2O2, Himedia) evaluation, and glucose fermentation (modified bromo cresol purple broth and 2% glucose as substrate procured from Himedia) [13]. The presence or absence of effervescence with H2O2 (3%) on the glass slide was recorded as positive or negative for the catalase test. The modified Bromo cresol purple broth with 2% glucose as a substrate was mixed with 2% of overnight grown culture and incubated for 24h at 37 °C. The color change in the medium due to alkaline by-products from the glucose fermentation confirms the lactic acid bacteria [13].
Phenotypic Evaluation of Colistin Resistance
Hi-Comb, and Double Disk Diffusion Test
Phenotypic resistance to colistin antibiotics is dependent on regulatory region and expression of mcr genes. Double disk and hi-comb strip diffusion tests were accompanied to establish phenotypic resistance among lactic acid bacteria towards polymyxin antibiotics according to the guidelines of the Clinical and Laboratory Standards Institute (CLSI) [14]. The double-disk test was performed using colistin (10 mcg; Himedia, Mumbai, India) and polymyxin B (300 U; Himedia, Mumbai, India). The Hi-comb strips of colistin and polymyxin B, with concentrations ranging from 0.01 to 240 μg in strip A and 0.001–30 μg in strip B (Himedia, Mumbai, India) were also used to assess the phenotypes of resistant LAB. All these tests were accomplished on MRS and incubated overnight at 37 °C for 18–24 h to analyze the results.
Determination of Minimum Inhibitory Concentration
The minimal inhibitory concentration (MIC) of colistin was performed using agar dilution and liquid broth dilution using 96-well microtiter plates in MRS broth according to [14] CLSI guidelines with cation-adjusted Mueller–Hinton Broth (Himedia, Mumbai, India) to evaluate the phenotypic antimicrobial resistance of test isolates to varied level of colistin. Viz., LAB susceptibility test medium i.e., 10% of MRS broth and 90% of LSM-Isosensitest broth (Himedia, Mumbai, India) supplemented with various concentrations of antibiotics were used according to CLSI [14] standards. The mid-log phase of cultures diluted properly was spotted on agar plates supplemented with colistin and other antibiotics at doubling of twofold dilution from 2 to 2048 μg/mL in 96-well microtiter plates and was incubated at 37 °C overnight. Quantification was performed using an ELISA reader (Model No.1510, Thermo Fischer Scientific, Vantaa, Finland). The well which has no growth under OD at 600 nm was recorded as the MIC values for antibiotics such as streptomycin (aminoglycoside) (Catalogue no: CMS220), vancomycin (glycopeptide) (Catalogue no: CMS217), erythromycin (macrolide) (Catalogue no: CMS528), clindamycin (lincosamide) (Catalogue no: CMS9386), colistin (polymyxin) (Catalogue no: CMS222), rifampicin (antimycobacterials) (Catalogue no: CMS1889), chloramphenicol (nitrobenzene antimicrobial) (Catalogue no: CMS218), tetracycline (broad-spectrum protein synthesis inhibitor) (Catalogue no: CMS219), kanamycin (aminoglycoside) (Catalogue no: CMS210), gentamicin (aminoglycoside) (Catalogue no: CMS461) and neomycin (aminoglycoside) (Catalogue no: CMS214) using 96-well microtiter plates [14, 15]. All reagents were purchased as reagent grade from commercial sources and used without further purification. The EFSA break point of colistin for Enterobacteriaceae is 4 mg/L and should occasionally be 2 or 8 mg/L. The current susceptibility testing for colistin faces significant challenges, and a collaborative effort by the CLSI-EUCAST Polymyxin Breakpoints Working Group has recently cautioned against the reliability of methods employed to evaluate the minimum inhibitory concentrations (MICs) of colistin-resistant isolates [16].
Biofilm Formation in the Presence of Colistin
Biofilm formation assay in microtiter plates was performed by overnight grown LAB strains LBA, LBB, LBF, and CHBI (1 × 107 cells/mL) was diluted in Iso-MRS broth, and 200 μl of this cell suspension was used per well together with colistin in doubling concentration i.e., 0 to 128 μg/mL. After 48 h of incubation at 37 °C, wells were gradually washed thrice using 200 μL of sterile phosphate-buffered saline (PBS) and air-dried in an inverted position. The biofilms were visually analyzed after staining with 0.1% crystal violet for 3 min. After staining, the adsorbed crystal violate was eluted using 200 μL of 70% v/v ethanol and absorbance measurements were taken with an ELISA (Model No: 1510, Thermofischer Scientific, Vantaa, Finland) reader at 590 nm with slight modification described by George and Halami. [17]. Each assay was performed in triplicate. The criteria of biofilm formation were the optical density (OD) value of biofilm formation was equal to or greater than twice that of the measured OD values of biofilm formation of the concerned culture without antibiotic (control).
Scanning Electron Microscopy (SEM) of the Isolates
The physical interaction during biofilm formation of the microbes was examined through Scanning Electron Microscopy (SEM). To study the morphology of LAB isolates after colistin induction, SEM analysis was performed on biofilm cells. The isolates were grown in MRS broth media with autoclaved 18mm coverslips in six-well polystyrene plates and incubated at 37 °C for 48 h. Then, the cells were washed with 100 mM PBS (pH 7.4) at room temperature. The samples were fixed with 2% glutaraldehyde solution for 4 h at 40 °C and then dehydrated by dipping into ethanol (20, 40, 80, and 99% thrice in each concentration). After sequential dehydration, the cells were dried, and gold-coated to be examined under a scanning electron microscope (VEGA\TESCAN, USA) at 15 kV for the topology of the LAB isolates with a magnification of 20,000 X [17].
Selection for Colistin Resistance in LAB at Sub-Inhibitory Concentrations
The two sensitive laboratory isolates i.e., Lactococcus sp. T3.11, and E3.11 taken as reference strains that grew in triplicates were exposed to ¼ MIC of colistin every 24 h for a duration of 28 days [17, 18]. The isolates were grown in an LAB susceptibility test medium i.e., 10% of MRS broth plus 90% of LSM-Isosensitest broth (Himedia, Mumbai, India), and with the exposure of colistin separately were serially passed for 7 days. The cultures of the 7th day were determined for MIC and its ¼ value was taken as the concentration for colistin selection for the successive second week. This serial passage of 1% inoculum with colistin selection for every 24 h and determination of MIC were followed for the 7th, 14th, 21st, and 28th days. At the end of every week, the cultures were sub-cultured and processed for DNA extraction.
Extraction and Preparation of DNA
DNA was extracted from the isolates collected on the 0th, 7th, 14th, 21st, and 28th days. The process involved taking 1 mL of cell culture suspension into a fresh eppendorf tube, centrifuging it at 8000 g for 10 min, discarding the supernatant, lysing, and purifying the pellet to extract DNA using the phenol–chloroform method [19]. Briefly, the obtained pellets were mixed with 150 μL of lysing buffer and incubated at 80 °C for 20 min. Proteinase K (Himedia, Mumbai, India) was added followed by incubation at 56 °C for 30 min. Then, 200 μL of equilibrium phenol was transferred to the tube spun down at 5000 rpm for 10 min. The upper aqueous layer containing DNA was mixed with 200 μL of chloroform (Himedia, Mumbai, India) and 20 μL of sodium acetate (Himedia, Mumbai, India), then centrifuged at 12,000 rpm for 10 min. After adding 120 μL of isopropanol and overnight incubation, the mixture was centrifuged at 12,000 rpm for 10 min at 4 °C. The supernatant was removed and 200 μl of 70% alcohol (Sigma, India) was added and centrifuged at 12,000 rpm for 4 min at 4 °C. The supernatant was completely discarded and the extracted DNA was stored in 30 μl nuclease-free water at −20 °C for later PCR analysis.
The DNA purity was assessed using a Nanodrop spectrophotometer (Thermo Fisher Scientific, USA). The absorbance ratios at A260/280 nm and A260/230 nm were measured to evaluate protein and salt/phenol contamination, respectively. Samples with an A260/280 ratio between 1.8 and 2.0, and an A260/230 ratio greater than 1.8 were selected for PCR analysis.
Determination of Mutation Gene
The presence of mutations in the 23S ribosomal DNA (rDNA) that cause colistin resistance was determined using primers mgrB-F (5′-AAGGCGTTCATTCTACCACC-3′) and mgrB-R (5′-TTAAGAAGGCCGTGCTATCC-3′) described by Zafer et al., [20] which was synthesized by Barcode Biosciences, Bangalore, India. The template DNA for the treated isolates was prepared as described earlier (Sect. 2.8). The amplification reaction mixture for all samples comprised 0.3U of Taq DNA polymerase, 1X PCR buffer, 0.5 mM dNTPs, 1.5 mM MgCl2, 1 μM of reverse and forward primer, 50–100 ng/μL of total DNA and DNase-free sterile water (ThermoFisher Scientific, USA). The PCR amplification of the mutation region in 23S ribosomal DNA (rDNA) using primers was performed under the following conditions: initial denaturation for 3 min at 95 °C, followed by 30 cycles of denaturation for 30 s at 95 °C, annealing at 54 °C for 30 s and extension for 105 s at 72 °C with final extension for 8 min at 72 °C. The product amplified (253 bp) [20] was examined on 1.8% agarose gel in TAE buffer and envisioned under a UV trans-illuminator.
Extraction of Bacterial DNA and Its Taxonomic Identification
DNA was extracted from the static condition of LAB isolates incubated for 12–14 h at 37 °C using the phenol–chloroform method (Sect. 2.8) [19]. The extracted DNA was stored in 30 μl nuclease-free water at −20 °C until used for PCR analysis. The taxonomic identification of LAB isolates was carried out using 16S rRNA amplification. The PCR mixture consisted of 0.3U of Taq DNA polymerase, 1X PCR buffer, 0.5 mM dNTPs, 1.5 mM MgCl2, 0.4 mM universal primers i.e., 8F- AGAGTTTGATCCTGGCTCAG and 1492R- GGTTACCTTGTTACGACTT (ThermoFisher Scientific, USA) [21]. The conditions for amplification include predenaturation (10 min at 95 °C) followed by 30 cycles of denaturation 1 min at 94 °C, annealing 1 min at 55 °C, extension 1.50 min at 72 °C, and final extension 7 min at 72 °C. The amplified PCR products were purified using a PCR purification kit and sequenced at Barcode Biosciences (Bangalore, India). The sequences were selected based on the maximum identity score, aligned with the ClustalW, and the phylogenetic trees were created using MEGA11 software by the neighbor-joining (NJ) method with the maximum likelihood for the best estimation of the relationship between different molecular sequences of the isolates.
Gene Sequencing and Nucleotide Accession Numbers
The obtained sequencing was subjected to BLAST search analysis to compare with the known sequence available in the NCBI database and the gene sequences have been deposited at the GenBank nucleotide sequence database for the accession number. The accession numbers for the 16S rRNA sequence of the isolates are MW295627.1 MW295629.1, and MW295630.1 for Levilactobacillus brevis LBB, Limosilactobacillus fermentum LBF and Pediococcus acidilactici CHBI respectively.
Detection of Colistin Resistance Genes
The resistant isolates were characterized for the presence of colistin-resistant genes by employing specific primers i.e., mcr1, mcr2, mcr3, mcr4, and mcr5 responsible for plasmid-mediated acquired colistin resistance [22]. The DNA extracted from each selected isolate was used as a template and the PCR reaction mixture for each primer amplification consisted of 0.3 U of Taq DNA polymerase, 1X PCR buffer, 0.5 mM dNTPs, 1.5 mM MgCl2, 1 μM of reverse and forward primer, 50–100 ng/μL of total DNA lysate and DNase-free sterile water. The PCR amplification of the colistin resistance region using primers was performed under the following conditions: 1 cycle of denaturation at 94 °C for 15 min, followed by 25 cycles of denaturation at 94 °C for 30 s, annealing at 58 °C for 90 s and elongation at 72 °C for 60 s, and a final cycle of elongation at 72 °C for 10 min. Particulars of the Primer sequence and the amplicon sizes are mentioned in Supplemental Table 1. The amplified PCR products were checked by electrophoresis using 1.8% agarose gel at 130 V followed by staining in ethidium-bromide and envisioned.
In Vitro Conjugation Experiments
Donor and Recipient Strains
To determine the transferability of the colistin-resistant respective donor (selected LAB isolated in this study i.e., LBB and CHBI) was crossed with the respective recipient, Lactococcus sp. E3.11 and Lactococcus sp. T3.11 (sensitive at 2 μg). MIC data were confirmed through the broth microdilution method described earlier in this study.
Conjugation Study
The in vitro conjugation was carried out by filter mating method as explained by Thumu and Halami, [23] with slight modification. The mid-exponential phase cultures of the donor and recipient strains were taken in a 1:1, 2:3, or 3:2 ratio, centrifuged for 10 min at 8000 rpm, and resuspended in peptone physiological saline (PPS). The mixture was then passed through a nitrocellulose filter and placed on MRS agar medium. The plates were incubated at 37 °C for 24–48 h. After incubation, the cells were diluted tenfold using PPS and plated on selective antibiotic medium to enumerate donor, recipient, and transconjugant cells i.e., for donor (colistin), recipient (rifampicin) and transconjugants (colistin and rifampicin). The resistance transfer frequency was calculated as the number of transconjugants divided by the number of donor or recipient cells. The experiments were repeated in triplicates and the average frequency was recorded.
Statistical Analysis
The respective criteria were represented by a bacterial species number value. The relative frequency (%) of the result values were given for each particular animal population. All data were presented as the arithmetic mean of three replicates (Mean ± standard deviation) and ANOVA-based statistics were applied to elaborate the significance of differences among various values. The significance level was set at 0.05.
Results
Sampling and Bacterial Enumeration of Antibiotic-Resistant LAB
The results of the analysis of all test food samples, including the total number of lactic counts with and without antibiotics, are shown in Fig. 1a. The normal microbiota in the food samples varied from 102 to 1010 CFU/mL in the absence of colistin (control), but in the presence of colistin, the microbiota ranged from 102 to 105 CFU/mL, with some samples showing no colonies.
The 68 isolates were tested for colistin resistance by spotting them on MRS media containing 4 µg/mL of colistin. All the isolated Lactic Acid Bacteria produced carbon-di-oxide during the glucose fermentation test and all were Gram-positive and negative for the catalase test. Out of 68 isolates, 35 were ruled out due to their sensitivity to colistin at 8 µg/mL, among them, 33 isolates were selected primarily according to their microscopic, morphologically larger colony size (> 3 mm) after 2 days of growth. From these tests, 4 isolates were selected based on the % survivability, and those 4 colistin-resistant lactic acid bacteria were chosen for further study to evaluate their potential for high resistance (CLSI) [14, 16]. These selected isolates (n = 4), screened from further Hichrome tests, were evaluated for their phenotypic resistance.
Phenotypic Evaluation of Colistin Resistance
Hi-Comb, and Double Disk Diffusion Test
The results of double disc diffusion tests and Hi-comb tests for selected LAB isolates are depicted in Fig. 1b. The result showed that LBA, LBB, LBF, and CHBI were resistant to colistin and polymyxin B. In the Hi-comb test, LBA and LBB displayed resistance when treated with antibiotic strips A and B of colistin and polymyxin B, whereas, CHBI exhibited resistance against A and B strips of colistin. However, CHBI showed resistance against strip A whereas resistance for strip B was till 30 µg of polymyxin B. The LBF isolate showed resistance against both colistin A and B strips but it was sensitive against A and B strips of polymyxin.
Minimum Inhibitory Concentration
This study includes four isolates for which colistin susceptibility was evaluated in vitro by broth microdilution method carried out in triplicate (Replicates A, B, and C). Colistin susceptibility testing was performed using broth microdilution following CLSI guidelines (CLSI M07-A9) and EUCAST epidemiological cut-off values (ECOFFs; http://www.eucast.org/) [24]. Although broth microdilution assay is recommended by the European Committee on Antimicrobial Susceptibility Testing (EUCAST) for determining MIC. The MIC distribution of the selected isolates is presented in Tables 1, 2. The three isolates i.e., LBA, LBB, and CHBI measured a MIC towards their upper MIC dilution limit (512 µg/mL) against colistin. Although, the MIC value for LBF was 256 µg/mL, which was lower than the other three organisms. Current study using the guidelines described that the antibiotic concentration of an isolate was designated as resistant (MIC ≥ 4 μg/mL) or susceptible (MIC ≤ 2 μg/mL) [25].
The minimum inhibitory concentration (MIC) of 11 antibiotics was analyzed for colistin-resistant LBA, LBB, LBF, and CHBI isolates and colistin (2 μg/mL) sensitive T3.11 and E3.11. (Tables 1, 2). The varied range of antibiotics MIC are Erythromycin ranging between 2 and 64 μg/mL, Clindamycin 8 to 64 μg/mL, Colistin 512 to 1024 μg/mL, Rifampicin 2 to 4 μg/mL, Chloramphenicol 32 to 128 μg/mL, Tetracycline 8 to 64 μg/mL, Kanamycin 256 to 512 μg/mL, Gentamycin 256 to 512 μg/mL, Neomycin 16 to 512 μg/mL, Streptomycin 16 to 256 μg/mL and Vancomycin 32 to 512 μg/mL (Table 1). Altogether, the strains LBF, LBB, LBA, and CHBI were found to be highly statistically significant compared to the sensitive strains T3.11 and E3.11 against multidrug resistance with P < 0.05 (Table 2). All four LAB isolates i.e., LBA, LBB, LBF, and CHBI except Lactococcus sp T3.11 and E3.11 showed resistance against almost all tested antibiotics. All resistant isolates were assigned a multidrug resistance index, categorizing them as either MDR (Multidrug-resistant) or XDR (Extensively drug-resistant), based on their resistance profiles to multiple antibiotics tested in this study (Table 3) [26].
Biofilm Formation in the Presence of Colistin
This study examined the biofilm-forming ability of LBA, LBB, LBF, and CHBI using CV assay and observed increased biofilm formation in colistin-resistant strains under nutrient-depleted conditions (Fig. 2). SEM and optical measurements confirmed the higher biofilm formation, which was accompanied by a higher number of physical appendages in colistin-resistant strains compared to susceptible ones [27]. The isolates showed different biofilm-forming capacities upon treatment with increasing concentrations of colistin (0.5 to 128 μg/mL). The maximum biofilm formation when treated with colistin was observed to be at increased concentrations of colistin.
Biofilm Formation and Growth of Selected Lactic Acid Bacteria under varying antibiotic conditions by crystal violet staining. Growth under minimal nutritional conditions with increasing antibiotic concentration showed a dose-dependent biofilm formation. Values indicated are the mean of triplicate readings + SD and are aligned with their respective stained rows on a 96-well plate after ethanol solubilization
All studied isolates LBA, LBB, LBF, and CHBI displayed a significant increase in biofilm formation at concentrations of 2 to 128 μg/mL, with consistently increasing biofilm formation observed with the increasing concentration of colistin (Fig. 2). The isolates also exhibited varying levels of phenotypic resistance to colistin when induced with higher concentrations of antibiotics and displayed a diverse range of biofilm formation.
Scanning Electron Microscopy (SEM) of the Isolate
The viability of cells forming biofilm in the presence of colistin was determined using a scanning electron microscope (SEM). The outer surface linkage production was visible in resistant LBA, LBB, LBF, and CHBI strains (Fig. 3) showing that their cell viability was higher than that of susceptible strains after exposure to colistin (Fig. 3).
Selection for Colistin Resistance in LAB at Sub-Inhibitory Concentrations
The antibiotic-induced reference strains (Lactococcus sp. E3.11 and T3.11) became more resistant to colistin after the serial passage technique of induction resistance. The new colistin MIC of this induction-resistant isolates T3.11 and E3.11 ranged from 2 μg/mL to 16 and 8 μg/mL respectively (Fig. 4a). Serial passage with colistin (1⁄4 MIC) showed a significant rise in the resistance ability against this selected antibiotic, on the 14th day of exposure to colistin (Fig. 4a). The resistance ability of isolate T3.11 increased two-fold during the first week and then increased four-fold by the end of the second week and E3. 11 increased two-fold during the first week and then increased two-fold by the end of the second week, which remained constant throughout the study period. This isolate demonstrated adaptability to colistin. By the 7th day of exposure to colistin, the MIC value was found to have increased. There was a significant and consistent increase in the MIC value over consecutive weeks in the presence of colistin.
Antibiotic resistance profile. a Minimum inhibitory concentration of Colistin-induced LAB isolates (*T3.11-Lactococcus sp. T3.11 and *E3.11-Lactococcus sp. E3.11); b Colistin-resistant mgrB gene (253 bp) present in Lactococcus sp T3.11 Lane1: M-Marker (75–5000 bp), Lane 2: B-Blank, Lane 3: T3.11 on 0th day, Lane 4: T3.11 on 7th day, Lane 5: T3.11 on 14th day, Lane 6: T3.11 on 21st day, and Lane 7: T3.11 on 28th day
Extraction and Preparation of DNA and Determination of Mutation Gene
The most common site for mutations that confer colistin resistance is in the mgrB gene, which was amplified using specific primers mgrB-f and mgrB-r [20]. In this study, reference isolate T3.11 showed a mutation in the mgrB gene after 7 days of colistin exposure till 28 days (Fig. 4b), which contributed to the observed increase in MICs for colistin. The amplification of the mutational mgrB gene from genomic DNA extracted on days 0th, 7th, 14th, 21st, and 28th was observed under UV transillumination. T3.11 exhibited an amplified 253 bp length mutational gene, while E3.11 did not exhibit amplification, indicating that the resistance mechanism of E3.11 may be different from the classical mechanism involving mgrB mutations [28].
Bacterial Strain Identification and Colistin Resistance Gene
Genomic DNA was isolated from selected colistin-resistant LAB isolates and subjected to qualitative and quantitative analysis, with a single sharp band visible on 0.8% agarose gel and an O.D 260/280 ratio of 1.8–2.0, indicating that the DNA was pure and suitable for use as a template in PCR analysis without protein or phenol contamination. PCR amplification using universal primers on these isolates revealed a 1400 bp band, with sequencing analysis showing 1% or no difference with the gene sequences available in the NCBI database. The partial sequences of 16S rRNA were submitted to GenBank and assigned accession numbers. The accession numbers for the 16S rRNA sequence of the isolated LBB, LBF, and CHBI, were MW295627.1, MW295629.1, and MW295630.1, respectively which were identified as Levilactobacillus brevis LBB, Limosilactobacillus fermentum LBF and Pediococcus acidilactici CHBI (Fig. 5a). The other isolate LBA which was 100% similar to Levilactobacillus brevis LBB, was not considered for the submission of the GenBank database, however, this was considered in this study because of different phenotypic characteristics, such as MIC, and biofilm formation. PCR amplification studies were conducted on all resistant LAB isolates to detect the presence of colistin-resistant genes. Positive amplification for mcr1 and mcr3 genes was obtained in Levilactobacillus brevis LBA, Levilactobacillus brevis LBB, and Pediococcus acidilactici CHBI (Fig. 5b), while there was no amplification of mcr genes in Limosilactobacillus fermentum LBF. Limosilactobacillus fermentum may contain other mcr genes besides mcr1-mcr5 for their degree of resistance.
a Phylogenetic tree showing the relative position of Levilactobacillus brevis LBB, Limosilactobacillus fermentum LBF, and Pediococcus acidilactici CHBI, using the neighbor-joining method of partial 16S rDNA sequences. Reference strains used for the comparison were selected from GenBank. Patrial 16S rRNA gene sequences were aligned using ClustalW, and phylogenetic inferences were obtained within the MEGA11 software with 1,000 bootstraps. The scale bar corresponds to a genetic distance substitution per position. Escherichia coli strain U541, Klebsiella pneumoniae strain R3, and Pseudomonas aeruginosa DS10-129 have been taken as an outgroup. b Genotypic detection of colistin-resistant genes among LAB isolates, Lane 1. Marker (10 kb), Lane 2. CHBI- Pediococcus acidilactici CHBI (929 bp), Lane 3. Levilactobacillus brevis LBB (320 bp), Lane 4. Levilactobacillus brevis LBA (320 bp), Lane 5. Pediococcus acidilactici CHBI
In Vitro Conjugation Experiments
The increasing prevalence of antimicrobial resistance poses a significant threat to public health, with conjugation being a major route for the dissemination of antibiotic resistance [23]. In this study, we aimed to investigate the potential transfer of antibiotic resistance from colistin-resistant lactic acid bacterial isolates obtained from food samples. However, we were unable to demonstrate the transfer of colistin-resistant genes mcr1-mcr5 genes, from Levilactobacillus brevis LBA, Levilactobacillus brevis LBB, and Pediococcus acidilactici CHBI (donor) to the sensitive Lactococcus sp. T3.11 and Lactococcus sp. E3.11 recipient used in this study.
Discussion
Most lactic acid bacteria used in animal-derived foods and animal feeds are known to originate from and reside in the gastrointestinal tract of animals [29]. Although lactic acid bacteria are termed Generally Regarded as Safe, the risk associated with the presence and horizontal transfer of antibiotic resistance genes cannot be ignored. A research investigation into the potential of LAB found in NONO, the traditionally fermented milk products underscores their role as reservoirs of antimicrobial resistance [30]. Another recent study reported that several Lactobacillus species exhibit notable resistance to aminoglycosides (kanamycin, streptomycin, amikacin, and gentamycin), glycopeptides such as vancomycin and teicoplanin, with vancomycin resistance being the most extensively characterized intrinsic resistance among lactobacilli [31]. The strains such as Lactobacilus helveticus, Leuconostoc mesenteroides, Lactococcus lactis, Lactobacillus delbrueckii subsp. bulgaricus, Lactococcus spp. Latilactobacillus curvatus, Lactiplantibacillus planturum, Lactiplantibacillus pentosus, Pediococcus pentosaceus isolated from yogurt, cheese, and meat are reported as multidrug-resistant to antibiotics such as ampicillin, ciprofloxacin, chloramphenicol, gentamicin, kanamycin, neomycin, streptomycin, vancomycin, clindamycin, lincomycin, rifampicin etc., [32]. Antibiotic resistance determinants were detected in lactobacilli exhibited significant phenotypic resistance to cephalosporins, aminoglycosides, quinolones, glycopeptides, and methicillin within the beta-lactam group isolated from fermented foods and humans. Additionally, they displayed sensitivity to macrolides, sulfonamides, and carbapenems [33]. In our current study, lactic acid bacterial isolates of (Levilactobacillus brevis LBA, Levilactobacillus brevis LBB, Limosilactobacillus fermentum LBF, and Pedioicoccus acidilactici CHBI) from chicken, and sheep intestines displayed resistance towards colistin antibiotics. These results were consistent with the LAB isolates obtained from fermented foods such as sausage, salami, ham, chorizo displayed resistance towards antibiotics such as rifampicin, erythromycin, vancomycin, polymyxin B, colistin [34]. The study conducted by Keter et al. [35] also revealed that Lactobacillus brevis MIM04 exhibited phenotypic multidrug resistance to vancomycin, ampicillin, cefotaxime, oxacillin, and gentamicin. Also, the Escherichia coli of swine-origin were reported to be multidrug-resistant including colistin-resistant at greater or equal to 16 μg/mL [36].
In this study, the phenotypic assay conducted to understand the resistance and susceptibility pattern revealed colistin and polymyxin B resistance in the LAB isolates. Phenotypic resistance to colistin and polymyxin B is generally dependent on the chromosomal mutation in genes associated with the alteration of the primary target of colistin, the lipid A of lipopolysaccharide, which is an adaptative strategy. Moreover, such modifications can be attained by the addition of phosphoethanolamine (PEtN) and 4-amino-4-deoxy-L-arabinose (L-Ara4N) to the phosphate groups of lipid A [7]. Additionally, the horizontally transferred plasmid carrying mcr genes encoding PEtN gained responsibility to resist the colistin. Traditional antimicrobial susceptibility testing (AST) procedures, such as broth microdilution and disc diffusion, were employed for measuring phenotypic colistin resistance in lactic acid bacteria. An alternative solution for AST is provided by genotypic approaches, which detect mcr genes using the PCR method, as compared to the phenotypic method [37]. The multidrug resistance pattern in the LAB isolates was observed in this study which was on par with the LAB isolates collected from animal feces of broiler chicken that were reported to be resistant to 15 antibiotics [38]. In the E-strip gradient test assessing susceptibility to 14 different antibiotics, more than 50% of LAB isolates from traditional fermented Indian food products exhibited resistance to ampicillin, chloramphenicol, ciprofloxacin, erythromycin, kanamycin, linezolid, streptomycin, trimethoprim, and vancomycin [39]. Antibiotic resistance and susceptibility of LAB isolates from marketed foods were also tested using a disc diffusion assay [33]. Earlier studies also explained that the failure to effectively treat infections with a large bacterial load may be due to the higher minimal inhibitory concentrations of these populations, compared to those determined in traditional laboratory tests [40]. The LAB isolates of animals used in food and fermentation industries have a higher pattern of antibiotic resistance. This may ensure that food animals are exposed to antibiotics used in farming that can spread throughout the food chain [41].
After phenotypic characterization, molecular characterization for taxonomic identification of highly polymyxin B and colistin-resistant LAB isolates from food-producing animals was carried out. The prevalence of resistant LAB isolates was also reported from the fermented food products [40, 41]. The ability of bacteria to form biofilms as a means to endure unfavorable conditions is influenced by their phenotypic resistance, reliant on associated genes, adhesin proteins, and the bacterial extracellular matrix. Health risks can arise, especially when colistin-resistant traits are transferred within biofilm communities, which comprise pathogenic organisms [42]. This study suggests that low concentrations of colistin may alter bacterial physiology, making them better adapted to survive and challenging infection eradication. It has been found that some organisms, like P. aeruginosa, produce biofilm at the air–liquid interface, while E. coli forms biofilms evenly across the well surface, leading to higher absorbance values after crystal violet staining [42]. Bacteria displayed various traits between planktonic states which are floating and sessile states that are adhered to the surface due to rapid changes in the expression levels of several genes associated with the maturation and production of exopolysaccharide (EPS), also known as “slime” or bacterial EPS, when bacteria attach to a surface [43]. In our study, the LAB isolates displayed an increase in biofilm formation that was proportional to the increase in colistin concentrations. These results can be compared with that of the study reported as increased subinhibitory concentrations of ampicillin, ceftriaxone, Fosfomycin, oxacillin, doxycycline, erythromycin, rifampicin, trimethoprim, linezolid, and spectinomycin were found to promote the biofilm formation by Enterococcus faecalis [44]. The significance of phenotypic changes observed in biofilms, resulting in genotypic alterations, cannot be overstated. After formation, bacteria within biofilms are shielded from the external environment. Communication is facilitated through signal transduction pathways, such as quorum sensing or two-component systems, leading to broad changes in gene expression, increased virulence, and accelerated acquisition of antibiotic resistance [5]. The generation of biofilms may be governed by a process that has not been carefully examined in this study. Although the growth rate and biofilm formation are impacted by higher antibiotic concentrations.
The analysis of sub-inhibitory levels of colistin inducing colistin resistance among the isolates performed in this study revealed higher tolerance to colistin after the serial passage technique to induce resistance. The sub-inhibitory doses of antibiotics are frequently exposed to the gut flora as a significant amount of antibiotics are utilized in poultry, livestock, and animal husbandry. As a result, gut commensals may have become resistant to most antibiotics [45]. In this study, the induction of colistin against sensitive Lactococcus sp. T3.11 and E3.11, revealed increased MIC value by two and four folds of colistin at 1/4th concentrations for every week up to 28th day. These results were on par with the study that reported an increase in the MIC values of Limosilactobacillus plantarum for antibiotics such as neomycin, streptomycin, kanamycin, and gentamycin after prolonged exposure to sub-inhibitory doses [46].
Mutations in mgrB lead to enhanced membrane stability and modifications in lipid A, which ultimately reduce the affinity of the antibiotic towards the cell [28]. The predominant molecular mechanisms responsible for colistin resistance involve the regulation of the pmrHFIJKLM operon by various proteins, including PmrAB, PmrD, PhoPQ, and MgrB [7]. Previous studies have shown that all mgrB genes can be mutated, leading to various mutations, including missense and frameshift mutations and complete deletions [28]. Mutations resulting from serial passage of isolates in an antibiotic environment have also been reported in other studies [47]. Also, the prolonged exposure to colistin led to the acquisition of resistance mechanisms, including mutations in genes such as mgrB, in Lactococcus spp. [48]. These findings are crucial for developing effective strategies to control the spread of antibiotic resistance.
The emergence of colistin resistance in food animals and the potential transmission of resistant strains to humans is of great concern. One of the primary mechanisms responsible for colistin resistance is the presence of the mcr gene, which encodes a phosphoethanolamine transferase that modifies the lipid A component of the bacterial outer membrane, reducing the affinity of colistin towards the cell [7]. In our study, we found the presence of mcr1 and mcr3 genes in lactic acid bacteria isolated from food animals. The presence of mcr genes in lactic acid bacteria (LAB) isolated from food animals is particularly worrying, as these organisms are frequently used as probiotics in both humans and animals [6]. The results of the study by Wang et al., [49] showed similar findings that 5 out of the 257 strains tested positive for the mcr-1 gene, all of which were isolated from meat samples. The authors noted that this finding raises concerns about the potential for the spread of colistin resistance through the food chain.
The transmission and mechanisms of antibiotic resistance and virulence are categorized into adaptive, innate, and acquired resistance. Physiological changes can be prompted by environmental factors, resulting in increased mutation rates; alterations in metabolic genes and regulatory processes; and activation of classic antibiotic inactivation and resistance mechanisms. This can potentially lead to the sharing of resistance and increased virulence among bacteria, resulting in acquired resistance [5]. The presence of these genes in food animals raises the possibility of their transfer to human-associated bacteria, resulting in the emergence of untreatable infections. Thus, strict monitoring and control measures are needed to prevent the spread of colistin resistance in food animal populations and to safeguard public health. The abundance of LAB in fermented foods and the gastrointestinal system, as well as other bacteria in the environment, all contribute to increased resistance to LAB. Amplified determinants can be transmitted to another host once a LAB develops resistance. As a result, it’s crucial to look for indications of transmissible antibiotic resistance in starting strains and bacteria used as feed and food additives.
Conclusion
The notion that lactobacilli present in food animals akin to levels found in other food sources, could serve as reservoirs for transferable colistin resistance genes to pathogens is a matter of profound concern, given its far-reaching implications for human health and food safety alike. This study highlights the emergence of colistin-resistant lactic acid bacteria (LAB) including Levilactobacillus brevis LBA, Levilactobacillus brevis LBB, Limosilactobacillus fermentum LBF and Pediococcus acidilactici CHBI in food animals, underscoring the necessity for responsible colistin usage as a last-resort antibiotic in clinical settings. The findings offer valuable insights for food safety and surveillance, particularly in developing countries where antibiotic resistance regulation is critical for controlling its spread via the food chain. Furthermore, the isolates demonstrated high resistance and biofilm-forming potential in nutrient-depleted conditions, with exposure to colistin induction leading to regrowth and potential resistance development. Phenotypic techniques are specified as complementary indicators of the presence of colistin-resistant LAB strains in the current study. Also, the present study identified the presence of colistin-resistant mcr-1 and mcr-3 genes in the genome of these selected LAB isolates. The prevalence of resistance among these bacterial species raises concerns over the use of antibiotics in non-medical sectors, such as veterinary practices and the food industry, as these practices may contribute to the spread of resistance, as demonstrated in this study. Further exploration of the transmissibility of these antibiotic resistance genes to other commensals is crucial to assess the safety of these isolates for probiotic and food fermentation applications. This study emphasizes the importance of optimizing colistin dosages and discouraging injudicious use of this life-saving antibiotic in poultry farms. Further research is necessary to fully elucidate the mechanisms of resistance in LAB, in greater detail.
Data Availability
All the generated or analyzed data during this study are included in the manuscript.
References
World Health Organization (2014) Antimicrobial resistance: global report on surveillance. World Health Organization, Geneva, Switzerland
Tzouvelekis LS, Markogiannakis A, Piperaki E, Souli M, Daikos GL (2014) Treating infections caused by carbapenemase-producing Enterobacteriaceae. Clin Microbiol Infect 20:862–872. https://doi.org/10.1111/1469-0691.12697
Shafiq M, Zeng M, Permana B, Bilal H, Huang J, Yao F, Algammal AM, Li X, Yuan Y, Jiao X (2022) Coexistence of blaNDM-5 and tet(X4) in international high-risk Escherichia coli clone ST648 of human origin in China. Front Microbiol 13:1031688. https://doi.org/10.3389/fmicb.2022.1031688
Poulakou G, Bassetti M, Righi E, Dimopoulos G (2014) Current and future treatment options for infections caused by multidrug-resistant Gram-negative pathogens. Future Microbiol 9:1053–1069. https://doi.org/10.2217/fmb.14.58
Schroeder M, Brooks BD, Brooks AE (2017) The complex relationship between virulence and antibiotic resistance. Genes (Basel) 8:39. https://doi.org/10.3390/genes8010039
Elbehiry A, Marzouk E, Aldubaib M, Moussa I, Abalkhail A, Ibrahem M, Hamada M, Sindi W, Alzaben F, Almuzaini AM, Algammal AM, Rawway M (2022) Pseudomonas species prevalence, protein analysis, and antibiotic resistance: an evolving public health challenge. AMB Express 12:53. https://doi.org/10.1186/s13568-022-01390-1
Ray M, Manjunath A, Halami PM (2022) Prevalence of polymyxin resistance through the food chain, the global crisis. J Antibiot 75:185–198. https://doi.org/10.1038/s41429-022-00502-0
Liu YY, Wang Y, Walsh TR, Yi LX, Zhang R, Spencer J et al (2016) Emergence of plasmid-mediated colistin resistance mechanism MCR-1 in animals and human beings in China: a microbiological and molecular biological study. Lancet Infect Dis 16:161–168. https://doi.org/10.1016/S1473-3099(15)00424-7
Sun J, Xu Y, Gao R, Lin J, Wei W, Srinivas S, Li D, Yang RS, Li XP, Liao XP, Liu YH, Feng Y (2017) Deciphering MCR-2 colistin resistance. MBio 8:e00625-17. https://doi.org/10.1128/mBio.00625-17
Schwarz S, Johnson AP (2016) Transferable resistance to colistin: a new but old threat. J Antimicrob Chemother 71:2066–2070. https://doi.org/10.1093/jac/dkw274
Kempf I, Jouy E, Chauvin C (2016) Colistin use and colistin resistance in bacteria from animals. Int J Antimicrob Agents 41:396–403. https://doi.org/10.1016/j.ijantimicag.2016.09.016
EFSA Panel on Additives and Products or Substances used in Animal Feed (FEEDAP) (2012) Guidance on the assessment of bacterial susceptibility to antimicrobials of human and veterinary importance. EFSA J 10:2740. https://doi.org/10.2903/j.efsa.2012.2740
Rotich MC (2018) Bio-prospecting for broad-spectrum antibiotic-producing actinomycetes isolated from virgin soils in Kericho county. Doctoral dissertation, JKUAT-COHES. http://hdl.handle.net/123456789/4517
CLSI document M–45 (2016) Methods for antimicrobial dilution and disk susceptibility testing of infrequently isolated or fastidious bacteria, 3rd edn. Clinical and Laboratory Standards Institute, Wayne
Abu-Dief AM, Alrashedee FM, Emran KM, Al-Abdulkarim HA (2022) Development of some magnetic metal-organic framework nanocomposites for pharmaceutical applications. Inorg Chem Commun 138:109251. https://doi.org/10.1016/j.inoche.2022.109251
European Committee on Antimicrobial Susceptibility Testing (2016) Recommendations for MIC determination of colistin (polymyxin E), as recommended by the joint CLSI-EUCAST Polymyxin Breakpoints Working Group. https://www.eucast.org/fileadmin/src/media/PDFs/EUCAST_files/General_documents/Recommendations_for_MIC_determination_of_colistin_March_2016.pdf
George J, Halami PM (2017) Sub-inhibitory concentrations of gentamicin triggers the expression of aac (6′) Ie-aph (2 ″) Ia, chaperons and biofilm related genes in Lactobacillus plantarum MCC 3011. Res Microbiol 168:722–731. https://doi.org/10.1016/j.resmic.2017.06.002
Yousefi Nojookambari N, Eslami G, Sadredinamin M, Vaezjalali M, Nikmanesh B, Dehbanipour R, Yazdansetad S, Ghalavand Z (2024) Sub-minimum inhibitory concentrations (sub-MICs) of colistin on Acinetobacter baumannii biofilm formation potency, adherence, and invasion to epithelial host cells: an experimental study in an Iranian children’s referral hospital. Microbiol Spectr 12:e0252323. https://doi.org/10.1128/spectrum.02523-23
Dairawan M, Shett PJ (2020) The evolution of DNA extraction methods. Am J Biomed Sci Res 8:39–45. https://doi.org/10.34297/AJBSR.2020.08.001234
Zafer MM, El-Mahallawy HA, Abdulhak A, Amin MA, Al-Agamy MH, Radwan HH (2019) Emergence of colistin resistance in multidrug-resistant Klebsiella pneumoniae and Escherichia coli strains isolated from cancer patients. Ann Clin Microbiol Antimicrob 18:40. https://doi.org/10.1186/s12941-019-0339-4
Fuks G, Elgart M, Amir A, Zeisel A, Turnbaugh PJ, Soen Y, Shental N (2018) Combining 16S rRNA gene variable regions enables high-resolution microbial community profiling. Microbiome 6:17. https://doi.org/10.1186/s40168-017-0396-x
Rebelo AR, Bortolaia V, Kjeldgaard JS, Pedersen SK, Leekitcharoenphon P, Hansen IM, Hendriksen RS (2018) Multiplex PCR for detection of plasmid-mediated colistin resistance determinants, mcr-1, mcr-2, mcr-3, mcr-4 and mcr-5 for surveillance purposes. Euro Surveill 23:17–00672. https://doi.org/10.2807/1560-7917.es.2018.23.6.17-00672
Thumu SCR, Halami PM (2019) Conjugal transfer of erm(B) and multiple tet genes from Lactobacillus spp. to bacterial pathogens in animal gut, in vitro and during food fermentation. Food Res Int 116:1066–1075. https://doi.org/10.1016/j.foodres.2018.09.046
Hindler JA, Humphries RM (2013) Colistin MIC variability by method for contemporary clinical isolates of multidrug-resistant Gram-negative bacilli. J Clin Microbiol 51:1678–1684. https://doi.org/10.1128/JCM.03385-12
Humphries RM, Abbott AN, Hindler JA (2019) Understanding and addressing CLSI breakpoint revisions: a primer for clinical laboratories. J Clin Microbiol 57:e00203-e219. https://doi.org/10.1128/JCM.00203-19
Magiorakos AP, Srinivasan A, Carey RB, Carmeli Y, Falagas ME, Giske CG et al (2012) Multidrug-resistant, extensively drug-resistant and pandrug-resistant bacteria: An international expert proposal for interim standard definitions for acquired resistance. Clin Microbiol Infect 18:268–281. https://doi.org/10.1111/j.1469-0691.2011.03570.x
Oluwole OM (2022) Biofilm: formation and natural products’ approach to control - a review. Afr J Infect Dis 16:59–71. https://doi.org/10.21010/Ajid.v16i2S.7
Yap PS, Cheng WH, Chang SK, Lim SE, Lai KS (2022) MgrB mutations and altered cell permeability in colistin resistance in Klebsiella pneumoniae. Cells 11:2995. https://doi.org/10.3390/cells11192995
Miranda C, Contente D, Igrejas G, Câmara SPA, Dapkevicius MLE, Poeta P (2021) Role of exposure to lactic acid bacteria from foods of animal origin in human health. Foods 10:2092. https://doi.org/10.3390/foods10092092
Obioha PI, Anyogu A, Awamaria B, Ghoddusi HB, Ouoba LII (2023) Antimicrobial resistance of lactic acid bacteria from Nono, a naturally fermented milk product. Antibiotics 12:843. https://doi.org/10.3390/antibiotics12050843
Nunziata L, Brasca M, Morandi S, Silvetti T (2022) Antibiotic resistance in wild and commercial non-enterococcal Lactic Acid Bacteria and Bifidobacteria strains of dairy origin: an update. Food Microbiol 104:103999. https://doi.org/10.1016/j.fm.2022.103999
Zarzecka U, Zadernowska A, Chajęcka-Wierzchowska W (2020) Starter cultures as a reservoir of antibiotic-resistant microorganisms. LWT 127:109424. https://doi.org/10.1016/j.lwt.2020.109424
Duche RT, Singh A, Wandhare AG, Sangwan V, Sihag MK, Nwagu TNT, Panwar H, Ezeogu LI (2023) Antibiotic resistance in potential probiotic lactic acid bacteria of fermented foods and human origin from Nigeria. BMC Microbiol 23:142. https://doi.org/10.1186/s12866-023-02883-0
Dudkiewicz A, Leonard J, Onarinde B, Zhao J (2019) Antimicrobial Resistance (AMR) Profiles of Lactic Acid Bacteria (LAB) Isolated from Fermented Meat Products of European Origin. University of Lincoln, Conference contribution. https://hdl.handle.net/10779/lincoln.25175348.v1
Keter MT, El Halfawy NM, El-Naggar MY (2022) Incidence of virulence determinants and antibiotic resistance in lactic acid bacteria isolated from food products. Future Microbiol 17:325–337. https://doi.org/10.2217/fmb-2021-0053
Al Atya AK, Abriouel H, Kempf I, Jouy E, Auclair E, Vachée A, Drider D (2016) Effects of colistin and bacteriocins combinations on the in vitro growth of Escherichia coli strains from swine origin. Probiotics Antimicrob proteins 8:183–190. https://doi.org/10.1007/s12602-016-9227-9
Li J, Xie S, Ahmed S, Wang F, Gu Y, Zhang C, Chai X, Wu Y, Cai J, Cheng G (2017) Antimicrobial activity and resistance: influencing factors. Front Pharmacol 8:364. https://doi.org/10.3389/fphar.2017.00364
Shazali N, Foo HL, Loh TC, Choe DW, Abdul Rahim R (2014) Prevalence of antibiotic resistance in lactic acid bacteria isolated from the feces of broiler chicken in Malaysia. Gut Pathog 6:1–7. https://doi.org/10.1186/1757-4749-6-1
Ojha AK, Shah NP, Mishra V, Emanuel N, Taneja NK (2023) Prevalence of antibiotic resistance in lactic acid bacteria isolated from traditional fermented Indian food products. Food Sci Biotechnol 32:2131–2143. https://doi.org/10.1007/s10068-023-01305-1
Al-Farraj ES, Alahmadi M, Mohamed WS, Alsaedi WH, Abu-Dief AM (2023) Development of VSe2@ Cu2Se nano-composites via facile one-pot hydrothermal method for pharmaceutical applications. Phys Scr 98:095004. https://doi.org/10.1088/1402-4896/aceada
Shahali A, Soltani R, Akbari V (2023) Probiotic Lactobacillus and the potential risk of spreading antibiotic resistance: a systematic review. Res Pharm Sci 18:468–477. https://doi.org/10.4103/1735-5362.383703
Vestby LK, Grønseth T, Simm R, Nesse LL (2020) Bacterial biofilm and its role in the pathogenesis of disease. Antibiotics (Basel) 9:59. https://doi.org/10.3390/antibiotics9020059
Sharma S, Mohler J, Mahajan SD, Schwartz SA, Bruggemann L, Aalinkeel R (2023) Microbial biofilm: a review on formation, infection, antibiotic resistance, control measures, and innovative treatment. Microorganisms 11:1614. https://doi.org/10.3390/microorganisms11061614
Yu W, Hallinen KM, Wood KB (2018) Interplay between antibiotic efficacy and drug-induced lysis underlies enhanced biofilm formation at subinhibitory drug concentrations. Antimicrob Agents Chemother 62:e01603-e1617. https://doi.org/10.1128/AAC.01603-17
WolleinWaldetoft K, Sundius S, Kuske R, Brown SP (2023) Defining the benefits of antibiotic resistance in commensals and the scope for resistance optimization. MBio 14:e0134922. https://doi.org/10.1128/mbio.01349-22
Shao Y, Zhang W, Guo H, Pan L, Zhang H, Sun T (2015) Comparative studies on antibiotic resistance in Lactobacillus casei and Lactobacillus plantarum. Food Control 50:250–258. https://doi.org/10.1016/j.foodcont.2014.09.003
Wistrand-Yuen E, Knopp M, Hjort K, Koskiniemi S, Berg OG, Andersson DI (2018) Evolution of high-level resistance during low-level antibiotic exposure. Nat Commun 9:1599. https://doi.org/10.1038/s41467-018-04059-1
Khoshbayan A, Narimisa N, Elahi Z, Bostanghadiri N, Razavi S, Shariati A (2024) Global prevalence of the mutation in the mgrB gene among clinical isolates of colistin-resistant Klebsiella pneumoniae: a systematic review and meta-analysis. Front Microbiol 15:1386478. https://doi.org/10.3389/fmicb.2024.1386478
Wang Q, Sun J, Li J, Ding Y, Li X (2021) Detection of mcr-1 gene in lactic acid bacteria strains isolated from food in China. J Food Prot 84:1226–1232. https://doi.org/10.4315/jfp-21-014
Funding
No external funding was used in the preparation of this article.
Author information
Authors and Affiliations
Contributions
MR and PH produced the idea for the research article; MR and MA performed the laboratory activities and drafted the article. MR, MA, and PH critically revised the article.
Corresponding author
Ethics declarations
Conflict of interest
MR, MA, and PH declare that there are no potential conflicts of interest that might be relevant to the contents of this article.
Ethics Approval
Not applicable.
Consent to Participate
Not applicable.
Consent for Publication
Not applicable.
Code Availability
Not applicable.
Additional information
Publisher's Note
Springer Nature remains neutral with regard to jurisdictional claims in published maps and institutional affiliations.
Supplementary Information
Below is the link to the electronic supplementary material.
Rights and permissions
Springer Nature or its licensor (e.g. a society or other partner) holds exclusive rights to this article under a publishing agreement with the author(s) or other rightsholder(s); author self-archiving of the accepted manuscript version of this article is solely governed by the terms of such publishing agreement and applicable law.
About this article
Cite this article
Ray, M., Ashwini, M. & Halami, P.M. The Occurrence of Colistin Resistance in Potential Lactic Acid Bacteria of Food-Producing Animals in India. Curr Microbiol 81, 297 (2024). https://doi.org/10.1007/s00284-024-03826-2
Received:
Accepted:
Published:
DOI: https://doi.org/10.1007/s00284-024-03826-2